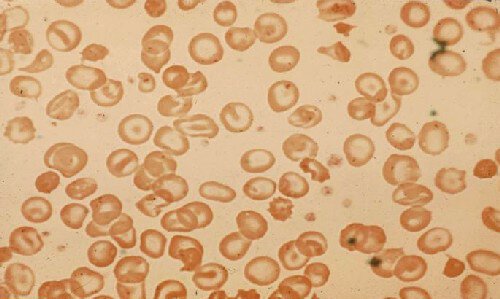

A 48-year-old man with alcoholic cirrhosis is evaluated for a rapidly progressive cellulitis 4 days after sustaining minor lacerations on his fingers while opening oysters.
Skin findings are shown.

Which of the following is the most likely infectious agent?
A. Bartonella henselae
B. Clostridium sordellii
C. Mycobacterium marinum
D. Vibrio vulnificus
D. Vibrio vulnificus
This patient has rapidly progressing necrotizing fasciitis caused by Vibrio vulnificus infection. V. vulnificus is found in warm waters throughout the world and is responsible for many serious infections in the United States each year as a result of exposure to shellfish and seawater, especially in patients with cirrhosis or other liver diseases.
Treatment involves emergent debridement. Appropriate antibiotic therapy is doxycycline plus (3rd gen cephalopsporin) ceftazidime
A 45-year-old woman is evaluated during a follow-up visit for newly diagnosed severe hypertension. She began low-dose hydrochlorothiazide and amlodipine therapy 1 month ago. There is no family history of hypertension. She has no other medical problems and takes no other medications.
On physical examination, blood pressure is 164/100 mm Hg in both arms, pulse rate is 76/min, and respiration rate is 18/min. BMI is 24. The remainder of the examination is normal.
Laboratory studies:
Bicarbonate 30 mEq/L (30 mmol/L)
Creatinine 0.9 mg/dL (79.6 µmol/L)
Potassium 2.9 mEq/L (2.9 mmol/L)
Sodium 138 mEq/L (138 mmol/L)
Urinalysis- No blood or protein
Which of the following is the most appropriate diagnostic test to perform next?
A. Plasma aldosterone concentration/plasma renin activity ratio
B. Plasma fractionated metanephrines measurement
C. Renal artery CT angiography
D. 24-Hour urine free cortisol measurement
A. Plasma aldosterone concentration/plasma renin activity ratio
Primary hyperaldosteronism, in which aldosterone production cannot be suppressed with sodium loading, is the most common cause of secondary hypertension in middle-aged adults and an important cause of resistant hypertension. A triad of resistant hypertension, metabolic alkalosis, and hypokalemia (including in patients treated with low-dose thiazide diuretics) should raise suspicion. Screening is recommended if any of the following are present: resistant hypertension; hypokalemia (spontaneous or substantial, if diuretic induced); incidentally discovered adrenal mass; family history of early-onset hypertension; moderately severe hypertension (>160/100 mm Hg); or stroke at age <40 years. It is common for patients with primary hyperaldosteronism to have normal serum potassium levels; a high index of suspicion is therefore required. This patient has substantial hypokalemia (serum potassium level of 2.9 mEq/L [2.9 mmol/L]) with initiation of low-dose hydrochlorothiazide and persistent, moderately severe hypertension. The patient also has a metabolic alkalosis.
A 75-year-old man is evaluated for 3 months of worsening exertional dyspnea, fatigue, and recent exertional chest pain that is relieved with rest.
On physical examination, blood pressure is 155/43 mm Hg, with rapid carotid upstrokes and collapse. A diminished S2, grade 2/6 early diastolic decrescendo murmur at the left sternal border, and displaced apical impulse are noted. Pulmonary crackles and elevated jugular pressure are present.
Which of the following is the most likely diagnosis?
A. Aortic regurgitation
B. Atrial myxoma
C. Patent ductus arteriosus
D. Tricuspid regurgitation
A. (Chronic) Aortic regurgitation
The characteristic murmur of valvular AR is a blowing diastolic decrescendo murmur heard best at the left third and fourth interspaces with the patient sitting and leaning forward. This patient's physical examination is consistent with severe AR, as evidenced by a Corrigan pulse in the carotid arteries (rapid, accentuated upstroke with a rapid decline), displaced apical impulse, and widened pulse pressure. AR is generally asymptomatic for a long time (possibly decades) until signs and symptoms of heart failure develop due to cardiac remodeling from chronic volume overload. Angina also may manifest because of subendocardial ischemia related to increased wall tension or reduced coronary perfusion pressure from reduced diastolic pressures. Congenital valve abnormalities (such as bicuspid aortic valve), rheumatic heart disease, abnormalities of the aortic sinuses or ascending aorta, prior infective endocarditis, or injury from prior radiation therapy may cause chronic AR.
Patients with an atrial myxoma (Option B) may present with constitutional symptoms related to interleukin production, embolic phenomena from tumor fragmentation, or symptoms referable to intracardiac obstruction (dyspnea, syncope). When mitral valvular obstruction is present, auscultatory findings are similar to those of mitral stenosis (mid-diastolic murmur heard best at the cardiac apex); however, findings may vary with position or be associated with an early diastolic sound, known as the tumor plop. This patient's findings do not support a diagnosis of atrial myxoma.
A patent ductus arteriosus (PDA) (Option C) is a persistent fetal connection between the aorta and the pulmonary artery. The typical murmur of a PDA is a continuous “machinery” murmur that envelops the S2, making it inaudible; the murmur is heard beneath the left clavicle. A tiny PDA is generally asymptomatic and inaudible. Patients with a moderate-sized PDA may present with bounding pulses, a wide pulse pressure, left-heart enlargement and dysfunction, and, rarely, clinical heart failure. This patient's early diastolic murmur localized to the left sternal border is not compatible with PDA.
This patient's physical examination reveals no evidence of significant tricuspid regurgitation (Option D), such as a systolic murmur, jugular venous distention, large retrograde v waves, or hepatojugular reflux.
A 25-year-old man is evaluated in the emergency department for a 1-week history of fatigue, dyspnea, and hemoptysis. He has no other medical problems and takes no medications.
On physical examination, blood pressure is 155/95 mm Hg, and respiration rate is 25/min; other vital signs are normal. No rash is noted. The remainder of the examination is unremarkable.
Laboratory studies:
C3 - 95 mg/dL (950 mg/L)
C4 - 20 mg/dL (200 mg/L)
Creatinine - 2.3 mg/dL (203.3 µmol/L)
Antinuclear antibodies - Negative
Antimyeloperoxidase antibodies- Negative
Antiproteinase-3 antibodies- Negative
Urinalysis
3+ blood; 3+ protein; numerous erythrocytes and erythrocyte casts
Kidney biopsy shows necrotizing and crescentic glomerulonephritis with linear staining for IgG on immunofluorescence.
Which of the following is the most appropriate serologic test to perform next?
A) Anti–double-stranded DNA antibodies
B) Anti–glomerular basement membrane antibodies
C) Anti–phospholipase A2 receptor antibodies
D) Circulating IgA levels
B) Anti–glomerular basement membrane antibodies
This patient has rapidly progressive glomerulonephritis (RPGN), defined as an acute and steep rise in serum creatinine accompanied by hematuria and proteinuria. The differential diagnosis for RPGN is divided histologically into three patterns on immunofluorescence microscopy of the kidney biopsy: pauci-immune staining (ANCA-mediated glomerulonephritis), linear staining (anti-GBM glomerulonephritis), and granular staining (lupus nephritis). This patient has RPGN and a kidney biopsy showing linear staining, which is seen in anti-GBM antibody disease. Lung involvement (Goodpasture syndrome) occurs in >50% of patients with anti-GBM antibody disease; hemoptysis can be a presenting symptom, although shortness of breath or cough should also raise suspicion for a pulmonary-renal syndrome even in the absence of hemoptysis. Testing for anti-GBM antibodies is required as the next step in management to confirm diagnosis. For this patient, anti-GBM antibody titers would also be used to monitor treatment response. Up to one in three patients with anti-GBM antibody disease will have positive ANCA serologies, usually antimyeloperoxidase (MPO) antibodies, which can affect prognosis. Combined seropositivity is most commonly seen in patients with anti-GBM antibody disease who are older women. Therefore, it is appropriate to test for p-ANCA/anti-MPO and c-ANCA/antiproteinase 3 antibodies. Successful treatment, which typically includes glucocorticoids, plasmapheresis, and cyclophosphamide, will eradicate the patient's serum anti-GBM antibody titer.
Testing for anti–double-stranded DNA antibodies (Option A) is not required in this patient, as his antinuclear antibody test is negative and his kidney biopsy shows no granular staining suggestive of lupus nephritis.
Anti–phospholipase A2 receptor antibodies (Option C) can be checked in patients suspected of having primary membranous nephropathy, which typically presents with the nephrotic syndrome and preserved kidney function. The findings of erythrocytes and erythrocyte casts also argue against primary membranous nephropathy.
IgA nephropathy (IgAN) can present with any of the manifestations of the nephritic syndrome. Diagnosis can only be made when kidney biopsy shows dominant mesangial immune deposits of IgA with C3, and occasionally IgG or IgM. Circulating IgA levels (Option D) are not diagnostically useful, nor can they be reliably correlated with disease activity and should not be obtained. This patient's kidney biopsy shows linear staining, which is not consistent with IgAN.
Where did Liz go to medical school?
Virginia Commonwealth University School of Medicine
A 55-year-old man is hospitalized for fever, chills, weakness, and malaise beginning earlier in the day. His dog scratched his right calf 4 days ago and has licked the site multiple times since. Medical history is notable for alcoholic cirrhosis. He takes no medications.
On physical examination, temperature is 38.8 °C (101.8 °F), blood pressure is 88/60 mm Hg, pulse rate is 120/min, and respiration rate is 25/min. A small tender cut is located on the right posterior calf with surrounding erythema and associated warmth.
Peripheral blood smear is shown.
Which of the following is the most likely cause of this infection?
A. Capnocytophaga canimorsus
B. Erysipelothrix rhusiopathiae
C. Mycobacterium marinum
D. Vibrio vulnificus
A. Capnocytophaga canimorsus
This patient with alcohol-associated cirrhosis and hyposplenism most likely has overwhelming sepsis from Capnocytophaga canimorsus infection (Option A). Life-threatening infection with this gram-negative bacillus/rod typically occurs after a dog (or cat) bite or scratch or exposure to dog saliva in patients with asplenia, functional hyposplenism, history of excessive alcohol use, or cirrhosis. Howell-Jolly bodies, nuclear remnants seen in erythrocytes, are typically seen in the setting of splenic hypofunction or asplenia. The increased risk for C. canimorsus infection in patients with asplenia/splenic hypofunction results from an impaired ability to clear intravascular bacteria and deficient antibody production. Management includes supportive care, empiric antibiotics with a carbapenem or a β-lactam/β-lactamase inhibitor combination, and possible surgical debridement.
Erysipelothrix rhusiopathiae (Option B) is a gram-positive rod that can infect animals, including swine and poultry, and is a saprophyte associated with fish, crustaceans, and mollusks. Exposure to these types of animals or their secretions can be occupationally acquired (fish and shellfish handlers, fishermen, butchers, and veterinarians). A painful, localized, violaceous, cutaneous infection of the hand or fingers (known as erysipeloid) classically develops at the site of trauma or a pre-existing wound. Fever is not often present.
Mycobacterium marinum (Option C) skin infections typically develop at sites of skin injury that have been exposed to salt or fresh water, such as in fish tanks (“fish tank granuloma”). The upper extremity is often involved, and lesions are usually papular before becoming ulcerative. Systemic toxicity is atypical.
Vibrio vulnificus (Option D) is a curved gram-negative bacillus that can cause sepsis and necrotizing fasciitis. Patients who are immunocompromised, particularly with liver disease, are at increased risk of infection. Hemorrhagic bullae are the classic cutaneous manifestation. Infection usually occurs after consumption of raw shellfish such as oysters or skin trauma incurred in warm sea water or brackish waters where the organism thrives.
A 51-year-old man is evaluated for resistant hypertension. He was first diagnosed with hypertension 10 years ago, and his blood pressure has been increasingly difficult to control. Medications are amlodipine, hydrochlorothiazide, and metoprolol.
On physical examination, his blood pressure is 164/82 mm Hg. The remainder of the examination is normal.
Laboratory testing for secondary causes of hypertension reveals primary aldosteronism.
A CT scan demonstrates a 1-cm left adrenal mass. Adrenal vein sampling does not reveal unilateral elevations in aldosterone levels.
Which of the following is the most appropriate treatment?
A. Bilateral adrenalectomy
B. Left adrenalectomy
C. Start lisinopril
D. Start spironolactone
D. Start spironolactone
Although an adrenal mass was noted on imaging, adrenal vein sampling demonstrated that this lesion is not producing aldosterone. Primary aldosteronism caused by hyperplasia of both adrenal glands (idiopathic hyperaldosteronism) is the most likely diagnosis. Idiopathic hyperaldosteronism causes approximately 60% of cases of primary aldosteronism; a unilateral aldosterone-producing adenoma (APA) is found in approximately 35% of cases. Medical therapy with an aldosterone receptor blocker, spironolactone or eplerenone, is the treatment of choice for idiopathic aldosteronism, or when patients with an aldosterone-producing adenoma are not candidates for or do not wish to undergo surgery. Spironolactone is often preferred over eplerenone because it is less expensive and has more potent aldosterone-blocking properties. However, patients on spironolactone are more likely to develop dose-dependent adverse effects, including gynecomastia and erectile dysfunction in men and menstrual irregularities in women.
Aldosterone has direct inflammatory and fibrotic effects that are independent of its blood pressure effects.
A 58-year-old man is evaluated for a 15-month history of chest pain, dyspnea, and occasional near-syncope with exertion. He has no cardiovascular risk factors and no other medical problems.
On physical examination, blood pressure is 110/85 mm Hg. Carotid upstroke is diminished and delayed. Cardiac examination shows a sustained apical impulse, grade 3/6 late-peaking systolic murmur, diminished S2, and an S4. Valsalva maneuver diminishes the intensity of the murmur.
Which of the following is the most likely diagnosis?
A. Aortic sclerosis
B. Aortic stenosis
C. Hypertrophic cardiomyopathy
D. Pulmonary arterial hypertension
B. Aortic stenosis
Classic manifestations of severe aortic stenosis (Option B) are angina, syncope, and heart failure. In early stages, aortic stenosis may present subtly, with dyspnea or a decrease in exercise tolerance. Approximately half of patients with aortic stenosis are diagnosed when heart failure develops. This patient has characteristic findings of severe aortic stenosis, including narrow pulse pressure; delayed and diminished carotid upstroke; sustained apical impulse; late-peaking systolic ejection murmur; and S4.
Aortic sclerosis (Option A) without stenosis is common finding in the elderly. Aortic sclerosis is asymptomatic and is discovered either on physical examination (systolic ejection murmur) or incidentally on echocardiography (aortic valve thickening without stenosis). Typical findings include a midsystolic soft and short ejection murmur heard best over the second right intercostal space. A normal carotid upstroke and normal S2 exclude aortic stenosis.
Most patients with hypertrophic cardiomyopathy (HCM) (Option C) are asymptomatic and have normal life expectancy, with diagnosis often resulting from evaluation of a heart murmur or abnormal ECG. Physical examination findings may be normal in patients without left ventricular outflow obstruction. The most common feature related to left ventricular outflow obstruction is a cardiac murmur, and dynamic maneuvers during examination are helpful in differentiating HCM from fixed valvular obstruction, such as aortic stenosis. HCM is associated with an ejection-quality murmur usually best heard at left lower sternal border; it generally does not radiate to the carotid arteries. Brisk carotid upstroke is present and may have two impulses for each ejection (bifid). The murmur of HCM increases in intensity of murmur during Valsalva strain phase. The murmur of aortic stenosis either does not change or is diminished during Valsalva strain phase
A 19-year-old woman is evaluated for a 2-week history of fatigue, poor appetite, arthralgia of the hands and knees, and a rash, all of which appeared 1 day after a trip to the beach. She has no other medical problems and takes no medications.
On physical examination, vital signs are normal. A malar rash characterized by pink-violet papules and plaques with sparing of the nasolabial folds is noted. The remainder of the examination, including joint examination, is normal.
Laboratory studies:
Albumin - 3.1 g/dL (31 g/L)
C3 - 50 mg/dL (500 mg/L)
C4 - 9 mg/dL (90 mg/L)
Creatinine - 1.1 mg/dL (97.2 µmol/L)
Antinuclear antibodies Titer, 1:160
Urinalysis
3+ blood; 3+ protein; many erythrocytes; occasional dysmorphic erythrocytes; rare erythrocyte casts
Kidney ultrasound shows kidneys of normal size and echogenicity.
Which of the following is the most appropriate diagnostic test to perform next?
A) Erythrocyte sedimentation rate
B) Extractable nuclear antigen panel
C) Kidney biopsy
D) Skin biopsy
C) Kidney biopsy
The 2019 European League Against Rheumatism/American College of Rheumatology classification criteria for systemic lupus erythematosus (SLE) include having antinuclear antibody (ANA) positivity at least once as obligatory entry criterion, followed by additive weighted criteria grouped into seven clinical and three immunologic domains. Patients with the entry criteria of a positive ANA, at least one clinical criterion, and having accumulated ≥10 points are classified as having SLE with a sensitivity of 96.1% and specificity of 93.4%. This patient has a positive ANA, acute cutaneous lupus erythematosus, and low serum complement levels (10 total points). The classic pattern of lupus nephritis is an immune complex–mediated glomerulonephritis with a varied pathology that includes six distinct classes of disease. The biopsy is crucial not only to establish the diagnosis but also to indicate which class of lupus nephritis she has, as the approach to treating lupus nephritis is guided by histologic class and the degree of kidney function impairment
This patient may test positive for one or more antibodies on the extractable nuclear antigen (ENA) (Option B) panel (e.g., anti-Smith, anti-U1-RNP, anti-Ro/SSA, anti-La/SSB), but this antibody panel test is not required to make a diagnosis of SLE. In addition, the results of an ENA panel are not expected to influence treatment plans compared with those of a kidney biopsy.
What is Sebastian's twin brother's name?
Gabriel
A 50-year-old woman is evaluated for fever, malaise, and the acute onset of the skin rash shown, which is associated with regional lymphadenopathy.

Which of the following is the most likely diagnosis?
A. Disseminated herpes simplex infection
B. Erysipelas
C. Staphylococcal scalded skin syndrome
D. Toxic shock syndrome
B. Erysipelas
This patient has facial erysipelas manifested as severe malar and periorbital bright erythema and swelling. Note the purulent discharge from the eye. Erysipelas refers to infection of the epidermis, upper dermis, and superficial lymphatics and is caused by the inoculation of the skin and subcutaneous tissue with streptococcal bacteria. Usually involving the face or lower extremities, this infection is brightly erythematous with distinct elevated borders and associated fever, lymphangitis, and regional lymphadenopathy.
Erysipelas is treated based on severity like cellulitis.
A 61-year-old woman is evaluated after an abdominal CT scan for diverticulitis revealed an incidental adrenal mass. She has no other medical problems and takes no medications.
On physical examination, vital signs are normal. The remainder of the examination is unremarkable.
Abdominal CT scan shows a 3.5-cm left adrenal mass with a density of 7 Hounsfield units and absolute contrast washout of 80% at 10 minutes. The remainder of the scan is normal.
Serum creatinine and electrolytes are normal. Testing for mild autonomous cortisol excess is negative.
Which of the following is the most appropriate next step in management?
A. Adrenal biopsy
B. Adrenalectomy
C. Screening for primary aldosteronism
D. Repeat abdominal CT at 12 months
D. Repeat abdominal CT at 12 months
The finding of an incidental adrenal mass prompts two key questions: (1) is the mass secreting excess hormone (aldosterone, cortisol, or catecholamines)?; and (2) is the mass benign or malignant? Biochemical testing for hypercortisolism should be undertaken in all patients with an incidentally discovered adrenal mass, even in the absence of typical symptoms; screening for pheochromocytoma is indicated if the unenhanced CT attenuation is greater than 10 Hounsfield units, even in the absence of hypertension. Most benign adrenal adenomas are smaller than 4 cm and have high lipid content, which corresponds to a density of less than 10 Hounsfield units, and contrast washout is greater than 60% in 10 minutes. This asymptomatic patient with an incidentally discovered adrenal mass has no evidence of hormone excess associated with mild autonomous cortisol excess and has a benign imaging phenotype. Clinical observation can also be considered. A large study of patients with small nonfunctioning adrenal tumors showed significant growth in only 2.5% of tumors at 50 months, and no cases of adrenal carcinoma were diagnosed. Clinically overt hormone excess developed in less than 0.1% of patients.
A 66-year-old man is evaluated for 90 minutes of crushing anterior chest pain.
On physical examination, blood pressure is 93/65 mm Hg and pulse rate is 112/min. The patient is diaphoretic. Pulsus paradoxus is absent. Jugular venous distension is present. Lungs are clear. Heart sounds are distant without murmur. ECG shows 2-mm ST-segment elevations in leads II, III, and aVF and 0.5-mm ST-segment elevation in lead V1.
Which of the following is the most likely diagnosis?
A. Cardiac tamponade
B. Pulmonary embolism
C. Right ventricular infarction
D. Ventricular septal rupture
C. Right ventricular infarction
In the setting of an inferior wall ST-elevation myocardial infarction, the triad of hypotension, clear lung fields, and jugular venous distention suggests a right ventricular infarction.
Treatment of right ventricular infarction consists of aggressive volume resuscitation to optimize right ventricular filling (preload), intravenous vasopressors if hypotension persists, and urgent coronary revascularization.
A 28-year-old man is evaluated for hematuria that he noted on awakening and a 3-day history of fever, runny nose, and cough. One year ago, he had an episode of gross hematuria after running a half marathon. Evaluation at that time resulted in a biopsy diagnosis of IgA nephropathy. He has no other medical problems and takes no medications.
On physical examination, temperature is 37.9 °C (100.2 °F), and blood pressure is 110/70 mm Hg; other vital signs are normal. The nasal mucosa is edematous, with serous discharge. Examination of the oropharynx reveals erythema without exudate. There is no lymphadenopathy. Lungs are clear to auscultation. The remainder of the examination is unremarkable.
Laboratory studies show a serum creatinine level of 0.9 mg/dL (79.6 µmol/L); urinalysis shows 3+ blood, trace protein, too numerous to count erythrocytes, and no casts. Streptococcal rapid antigen test is negative.
Which of the following is the most appropriate management?
A) Amoxicillin
B) CT of the abdomen and pelvis
C) Prednisone
D) Clinical observation
D) Clinical observation
This patient can be reassured that the gross hematuria is related to his underlying IgA nephropathy and will resolve spontaneously. Recurrent gross hematuria, in which the hematuria occurs in the setting of an upper respiratory infection (synpharyngitic hematuria) or after heavy exertion, is a common manifestation of IgA nephropathy in younger patients; it usually portends a benign clinical course with recurrent episodes of gross hematuria without progression to chronic kidney disease. Other predictors of a benign prognosis include a normal serum creatinine concentration and blood pressure as well as minimal proteinuria.
Glucocorticoid therapy, such as with prednisone (Option C), is unnecessary in a mild form of nonprogressive IgA nephropathy. The use of immunosuppression in progressive IgA nephropathy remains controversial: The STOP-IgAN study showed no benefit of glucocorticoid therapy in slowing the decline of kidney function, and the TESTING study was terminated early due to significantly increased risk for adverse events in patients treated with glucocorticoids. Therefore, glucocorticoid therapy is reserved for severe forms of IgA nephropathy deemed high risk for rapid progression to end-stage kidney disease.
In which state was Liz born?
Texas
A 45-year-old woman is evaluated in the emergency department for a bite on her hand sustained several hours earlier; the bite is from a toddler in her day care class. Medical history is significant for type 2 diabetes and anaphylactic reaction to penicillin. She received the tetanus toxoid, reduced diphtheria toxoid, and acellular pertussis vaccine (Tdap) 1 year ago. Medications are metformin and empagliflozin.
On physical examination, vital signs are normal. A few tiny puncture wounds with minimal erythema are noted over the dorsum of the left hand.
Radiographs of the left hand reveal no evidence of a foreign body, gas, or bone involvement. The wound is irrigated and evaluated by a surgical hand expert, and no surgical intervention is required.
Which of the following is the most appropriate treatment?
A. Amoxicillin-clavulanate
B. Levofloxacin and metronidazole
C. Tetanus vaccination
D. Observation
B. Levofloxacin and metronidazole
Antibiotic prophylaxis is indicated following a human bite involving the hand or in immunocompromised patients.
In patients not allergic to penicillin requiring antibiotic prophylaxis following a human bite, amoxicillin-clavulanate is preferred.
Oral amoxicillin-clavulanate (Option A), the preferred agent, is contraindicated because of her history of anaphylaxis following penicillin use.
Although antibiotic prophylaxis is not routinely recommended (Option D) after a human bite, this patient's immunocompromised state and the involvement of the hand increase the risk of infection and warrant antibiotic prophylaxis.
A 55-year-old man is evaluated for primary aldosteronism. He has resistant hypertension despite therapy with three drugs at adequate dosages, including a diuretic. He has no other medical concerns. Medications are hydrochlorothiazide, amlodipine, and losartan.
On physical examination, blood pressure is 152/98 mm Hg and pulse rate is 72/min. The remainder of the vital signs and physical examination are unremarkable.
Serum electrolytes are normal.
Which of the following is the most appropriate test?
A. Adrenal CT
B. Aldosterone measurement after oral sodium loading
C. 24-Hour urine potassium measurement
D. Plasma renin activity measurement
D. Plasma renin activity measurement
Screening for primary hyperaldosteronism in patients with hypertension is recommended if any of the following are present: resistant hypertension, hypokalemia (spontaneous or substantial, if diuretic induced), incidentally discovered adrenal mass, family history of early-onset hypertension, or stroke at younger than 40 years. The most reliable case-detection test is calculation of plasma aldosterone concentration (PAC)/PRA by measuring PAC and PRA (or direct renin concentration) in a midmorning seated sample. In patients taking an ACE inhibitor or an angiotensin receptor blocker, PRA should be elevated; therefore, a simple initial test in these patients is a PRA measurement. If PRA is suppressed, the likelihood of primary aldosteronism is high and then PAC/PRA should be calculated; if PRA is elevated, hyperaldosteronism is ruled out. This patient is taking losartan, an angiotensin receptor blocker, and the initial test can be a PRA measurement.
A 76-year-old woman is evaluated in the emergency department for an episode of near-syncope. She has also had progressive dyspnea and nonproductive cough over a 3-week period and an unintentional weight loss of 4.1 kg (9 lb) over the past 3 months. She reports no fever. She has a 50-pack-year history of cigarette smoking, but she stopped smoking 3 weeks ago.
On physical examination, the patient is afebrile. Blood pressure is 132/60 mm Hg, with a fall in systolic pressure of 24 mm Hg during inspiration. Pulse rate is 110/min and regular. Oxygen saturation is 90% with the patient breathing ambient air. BMI is 17. Jugular venous distention is present. Heart sounds are distant. Crackles are present at the lung bases.
A chest radiograph shows a 6-cm right upper lobe mass and an enlarged cardiac silhouette.
Which of the following is the most appropriate diagnostic test?
A. Cardiac catheterization
B. CT-directed needle biopsy
C. Fiberoptic bronchoscopy
D. PET/CT
E. Transthoracic echocardiography
E. Transthoracic echocardiography
Symptoms of progressive dyspnea may be caused by underlying pulmonary or cardiac disorders, but this patient's physical findings, including a significant pulsus paradoxus (24 mm Hg), tachycardia, distant heart sounds, and crackles, as well as an enlarged cardiac silhouette on chest radiograph, suggest the life-threatening diagnosis of cardiac tamponade. Pulsus paradoxus represents exaggerated ventricular interdependence and is a key clinical feature of cardiac tamponade. It is characterized by a fall in systolic pressure of greater than 10 mm Hg during inspiration. Pulsus paradoxus is not specific for tamponade and must be interpreted in conjunction with other clinical and echocardiographic features. If the fluid has accumulated slowly, the cardiac silhouette is typically enlarged on chest radiograph. This patient's findings should prompt urgent evaluation for cardiac tamponade and treatment if present. Echocardiography to evaluate for the presence, distribution, and relative volume of pericardial fluid is important to establish the diagnosis.
Right heart catheterization (Option A) might confirm hemodynamic findings consistent with tamponade, and pericardiocentesis could be performed within the cardiac catheterization laboratory. TTE to evaluate for a pericardial effusion and tamponade should precede any invasive evaluation or therapeutic procedure because it is safe and readily available.
A 33-year-old man is evaluated for asymptomatic microscopic hematuria. Urinalysis is performed.
Urine microscopy is shown.

Which of the following is the most likely diagnosis?
A) Acute tubular necrosis
B) Glomerulonephritis
C) Interstitial nephritis
D) Pyelonephritis
Glomerulonephritis is the most likely diagnosis. This patient's urinalysis shows an erythrocyte cast and indicates glomerular disease. Erythrocytes may be distinct or incorporated into a homogenous mass. The most characteristic feature of an erythrocyte cast, when present, is its orange-red appearance. The glomerular hematuria seen in the nephritic syndrome can be distinguished from other causes of urinary tract bleeding by the presence of either dysmorphic erythrocytes (resulting from distortion that occurs as they pass through the glomerular basement membrane and then along the renal tubules) or erythrocyte casts on urine microscopy. Red blood cells lack a nucleus, which helps to distinguish them for other nucleated cell types. Common features of glomerulonephritis are hematuria (microscopic or macroscopic) and proteinuria, with the more severe forms typically including hypertension, edema, and kidney dysfunction (elevated serum creatinine).
Where is Sebastian's family from?
Puerto Rico
A 42-year-old man is evaluated in the emergency department for a 2-day history of redness and pain at the site of a recent insect bite. Medical history is otherwise noncontributory, and he takes no medications.
On physical examination, temperature is 38.8 °C (101.9 °F), blood pressure is 110/70 mm Hg, pulse rate is 105/min, and respiration rate is 18/min. A poorly defined, diffuse, 4- × 5-cm erythematous area is located on the distal left lower extremity; it is warm and edematous but without purulence, induration, or fluctuance. No other findings are present.
Laboratory studies show a leukocyte count of 15,000/µL (15 × 109/L).
Which of the following is the most appropriate antibiotic therapy?
A. Cefazolin
B. Doxycycline
C. Trimethoprim-sulfamethoxazole
D. Vancomycin
E. Vancomycin and piperacillin-tazobactam
A. Cefazolin
He has systemic signs of infection (fever, tachycardia, leukocytosis) indicating moderate severity nonpurulent cellulitis of the left lower extremity. For moderate severity cellulitis, the Infectious Diseases Society of America recommends intravenous antibiotics directed against β-hemolytic streptococci, including penicillin, ceftriaxone, cefazolin, or clindamycin. Nonpurulent skin infections include erysipelas and cellulitis. Erysipelas refers to infection of the epidermis, upper dermis, and superficial lymphatics. Usually involving the face or lower extremities, this infection is brightly erythematous with distinct, elevated borders and associated fever, lymphangitis, and regional lymphadenopathy. Cellulitis refers to infection involving the deeper dermis and subcutaneous fat tissue. Inflammatory signs of infection are similar to erysipelas, but the area of involvement is less well demarcated. For immunocompetent patients with cellulitis or erysipelas who have no systemic signs or symptoms (i.e., mild infection), oral therapy, including penicillin VK, cephalexin, dicloxacillin, or clindamycin, directed against streptococci is recommended.
In addition to incision and drainage, empiric therapy against Staphylococcus aureus (MRSA) with doxycycline or trimethoprim-sulfamethoxazole (Option B, C) is recommended for moderate purulent skin infections with systemic signs of infection, which is not apparent in this case.
Vancomycin (Option D) provides coverage against streptococci and MRSA and is recommended when nonpurulent cellulitis requiring intravenous antibiotics is associated with penetrating trauma, nasal colonization or infection with MRSA elsewhere, or injection drug use. None of these conditions is evident in this patient, so vancomycin is not indicated.
Necrotizing soft tissue infections, which involve subdermal compartments (fascia and possibly muscle) are uncommon but potentially life threatening. Necrotizing fasciitis initially resembles cellulitis before potentially rapid progression with edema, severe pain, hemorrhagic bullous lesions, skin necrosis, and local crepitus. Systemic toxicity manifests with fever, hypotension, tachycardia, mental status changes, and tachypnea. A hallmark of infection is “woody” induration appreciated by palpation of involved subcutaneous tissues. Pending culture results, empiric antibiotic treatment includes broad-spectrum coverage for aerobic and anaerobic organisms (including MRSA) and consists of vancomycin, daptomycin, or linezolid plus piperacillin-tazobactam (Option E);
A 73-year-old woman is seen during a routine evaluation. She has been taking amiodarone for atrial fibrillation for 1 year with good control until a recurrence 1 week ago. Thyroid function tests were normal before starting amiodarone. She has no history of iodinated contrast use. She is otherwise well and takes no additional medications.
On physical examination, pulse rate is 110/min and irregular; remaining vital signs are normal. Other than an irregular tachycardia, the thyroid and remainder of the examination are normal.
Laboratory studies show a thyroid-stimulating hormone level of less than 0.01 μU/mL (0.01 mU/L) and free thyroxine level of 3.5 ng/dL (45.0 pmol/L).
ECG shows atrial fibrillation.
Which of the following is the most appropriate diagnostic test?
A. Serum thyroglobulin measurement
B. Thyroid peroxidase antibody titer
C. Thyroid scintigraphy with radioactive iodine uptake
D. Thyroid ultrasonography with Doppler studies
D. Thyroid ultrasonography with Doppler studies
This patient has developed thyrotoxicosis while taking amiodarone. Amiodarone has a high iodine content (37%) and prolonged half-life of approximately 60 days or longer. Thyrotoxicosis affects 5% of patients treated with amiodarone. Type 1 amiodarone-induced thyrotoxicosis (AIT) (hyperthyroidism) occurs in patients with Graves disease or thyroid nodules. This form of iodine-induced hyperthyroidism (Jod-Basedow phenomenon) is typically treated with methimazole. Type 2 AIT (destructive thyroiditis) is more common and occurs in patients without underlying thyroid disease. Type 2 AIT is usually self-limiting but sometimes requires treatment with glucocorticoids. Thyroid ultrasonography with Doppler studies, in addition to identifying thyroid nodules, allows assessment of the gland vascularity. Increased vascularity suggests type 1 AIT as the cause, whereas decreased vascularity suggests type 2 AIT. The decision to discontinue amiodarone depends on the patient's cardiac condition and type of thyrotoxicosis and should be done in consultation with a cardiologist.
The evaluation of AIT with thyroid scintigraphy is difficult and unreliable, however, because the high iodine load from amiodarone impairs thyroid uptake of iodine.
An 18-year-old man is evaluated for a heart murmur noted on a preparticipation sports examination. He remembers being told about a murmur in the past, but he has had no prior testing or intervention. He is asymptomatic, without known medical problems, and takes no medications.
On physical examination, vital signs are normal. The estimated central venous pressure is normal. Apical impulse is normal, and a thrill is noted along the left sternal border. A grade 4/6 holosystolic murmur is heard at the left sternal border, obscuring the S2. The remainder of the physical examination is unremarkable.
An ECG and chest radiograph are normal.
Which of the following is the most likely diagnosis?
A. Atrial septal defect
B. Coarctation of the aorta
C. Patent ductus arteriosus
D. Ventricular septal defect
D. Ventricular septal defect
The presentation of an isolated VSD depends on the VSD size and pulmonary vascular resistance. Small VSDs are usually asymptomatic. A palpable systolic murmur (thrill) is often noted at the left sternal border, accompanied by a loud holosystolic murmur that obliterates the S2, as observed in this patient. Small VSDs do not cause left heart enlargement or pulmonary hypertension, and the ECG and chest radiograph reveal normal findings. VSD closure is not indicated for patients with a small left-to-right shunt and no chamber enlargement or valve disease, but periodic clinical evaluation and imaging are recommended. Patients with small VSDs do not require activity restrictions.
An adult with an atrial septal defect (ASD) (Option A) most often presents with dyspnea, atrial arrhythmias, or right heart enlargement. Physical examination findings include elevation in venous pressure, a right ventricular lift, fixed splitting of the S2, a pulmonary midsystolic flow murmur, and, when there is a large shunt, a tricuspid diastolic flow rumble. The ECG demonstrates right axis deviation and incomplete right bundle branch block, and the chest radiograph generally demonstrates features of right heart enlargement and enlarged pulmonary arteries with increased pulmonary blood flow.
Typical physical examination findings in aortic coarctation (Option B) include upper extremity hypertension, radial artery–to–femoral artery pulse and blood pressure differentials, and a systolic murmur over the left chest related to obstruction from the coarctation. In addition, findings of bicuspid aortic valve, including ejection click and systolic ejection murmur, are commonly present, as more than 50% of patients with coarctation also have a bicuspid aortic valve. The ECG demonstrates left ventricular hypertrophy, and a typical chest radiograph shows abnormal aortic contour and rib notching.
A small patent ductus arteriosus (PDA) (Option C) generally causes no cardiovascular symptoms. A continuous murmur heard beneath the left clavicle that envelops the S2 is typical. Occasionally, no murmur is heard, and the diagnosis is made by echocardiography. The ECG and chest radiograph are normal in a patient with a small PDA.
A 69-year-old man is evaluated 7 days after starting nafcillin to treat a culture-proven methicillin-sensitive Staphylococcal aureus sternal wound infection. The infection was diagnosed 10 days after coronary artery bypass surgery. History is significant for diabetes mellitus. Other medications are aspirin, metformin, metoprolol, atorvastatin, and acetaminophen as needed.
On physical examination, vital signs are normal. The sternal wound appears to be healing, with minimal tenderness and redness and decreased drainage. The remainder of the examination is unremarkable.
Laboratory studies:
C3 - 61 mg/dL (610 mg/L)
C4 - 13 mg/dL (130 mg/L)
Creatinine -2.0 mg/dL (176.8 µmol/L); before hospital admission: 0.9 mg/dL (79.6 µmol/L)
Urinalysis
3+ blood; 2+ protein; 30-40 erythrocytes/hpf; 2-5 leukocytes/hpf; dysmorphic erythrocytes; rare erythrocyte casts
Kidney biopsy shows a mild proliferative glomerulonephritis with infiltrating neutrophils, granular C3, and IgG and IgM staining on immunofluorescence; hump-shaped subepithelial electron-dense deposits are seen on electron microscopy.
Which of the following is the most appropriate treatment?
A) Add lisinopril
B) Add prednisone
C) Continue nafcillin
D) Initiate sodium restriction and furosemide
C) Continue nafcillin
Continuing nafcillin (Option C) is the most appropriate treatment for this patient with infection-related glomerulonephritis (IRGN). IRGN results from a recently resolved infection or an ongoing infection at the time of development of glomerulonephritis. Diabetes mellitus is the most common comorbidity, and older age (>65 years) is a key risk factor; both factors are present in this patient. Treatment of IRGN is typically supportive and aimed at the infectious etiology.
The prognosis for complete recovery from IRGN is excellent in children. However, in adults, the prognosis of the newly recognized forms of IRGN (e.g., due to Staphylococcus aureus and gram-negative organisms) is less favorable, with more patients developing severe kidney dysfunction, progressing to chronic kidney disease (CKD) and sometimes to end-stage kidney disease. Initiation of an ACE inhibitor such as lisinopril (Option A) at the time of acute kidney injury is not recommended. However, in this patient's long-term follow-up, lisinopril therapy is a reasonable option if he develops proteinuric CKD as a residual of IRGN.
Adding a trial of glucocorticoid therapy such as prednisone (Option B) to antibiotic therapy for IRGN is considered only in rare cases in which a severe proliferative glomerulonephritis on biopsy is accompanied by a rapid progression toward kidney failure. In this patient, the glomerular lesion is not described as severe, and his serum creatinine levels during his hospitalization do not indicate rapidly progressive glomerulonephritis defined by at least a 50% decline in glomerular filtration rate over a short time period.
The indication for diuretics and sodium restriction is the presence of hypertension and edema secondary to fluid retention. In these cases, sodium restriction and a loop diuretic (Option D) are recommended first-line therapies. Because this patient does not have evidence of hypertension or edema, these therapies are not indicated.
How old is Sebastian?
31